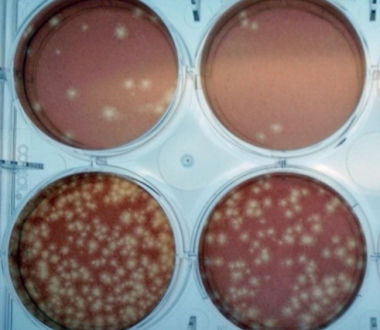

The study is published in the Centers for Disease Control and Prevention's Morbidity and Mortality Weekly Report.
The Department issues a joint Health Advisory to health care providers related to increased Oropouche virus activity and associated risk to travelers.
Read the New York State Department of Health's press release.